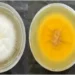
Primeiro caso e surto: os superfungos que preocupam hospitais brasileiros

Nos últimos meses, temos acompanhado uma enxurrada de informações sobre a pandemia de Covid-19. Desde o início da propagação do vírus, diversas pesquisas e estudos têm sido realizados para entender melhor a doença e encontrar formas de combatê-la. No entanto, alguns resultados de pesquisa têm sido distorcidos e utilizados como arma retórica por grupos inconformados com a condução da pandemia, causando desinformação e prejudicando os esforços de combate à doença.
A pandemia de Covid-19 trouxe à tona uma realidade preocupante: a disseminação de informações falsas e a manipulação de dados científicos. Com o avanço da tecnologia e a facilidade de compartilhamento de informações, muitas pessoas têm utilizado as redes sociais e outros meios para disseminar notícias falsas e teorias conspiratórias sobre a pandemia. Isso tem gerado um clima de desconfiança e incertezas em relação às medidas adotadas pelos governos e autoridades de saúde.
Um dos principais alvos dessas informações distorcidas são os resultados de pesquisas científicas. Muitas vezes, esses resultados são utilizados de forma isolada e fora de contexto, com o intuito de comprovar teorias conspiratórias e desacreditar as medidas de combate à pandemia. Isso tem gerado uma grande confusão entre a população e dificultado a compreensão da gravidade da situação.
Além disso, alguns grupos inconformados com a condução da pandemia têm utilizado esses resultados de pesquisa de forma tendenciosa, com o objetivo de manipular a opinião pública e criar uma falsa sensação de que a situação está sob controle. Isso pode ser extremamente perigoso, pois desencoraja as pessoas a seguirem as medidas de prevenção e pode contribuir para o aumento dos casos de Covid-19.
É importante ressaltar que os resultados de pesquisa são apenas uma parte do processo científico. Eles devem ser interpretados e analisados de forma criteriosa, levando em consideração diversos fatores, como a metodologia utilizada, o tamanho da amostra e a validade dos dados. Além disso, é fundamental que esses resultados sejam divulgados de forma clara e transparente, sem a intenção de manipular ou distorcer a realidade.
É compreensível que, diante de uma situação tão complexa e incerta como a pandemia de Covid-19, as pessoas busquem respostas e explicações para o que está acontecendo. No entanto, é preciso ter cuidado com a fonte das informações e verificar sua veracidade antes de compartilhá-las. A disseminação de notícias falsas e a manipulação de dados científicos podem causar danos irreparáveis à saúde e à sociedade como um todo.
Portanto, é fundamental que a população esteja atenta e consciente sobre a importância de seguir as medidas de prevenção recomendadas pelas autoridades de saúde. Além disso, é necessário que os resultados de pesquisa sejam divulgados de forma responsável e ética, sem a intenção de manipular a opinião pública. Somente assim poderemos enfrentar a pandemia de forma eficaz e superar esse momento difícil.
Para concluir, é preciso que todos tenhamos consciência de que os resultados de pesquisa são fundamentais para o avanço científico e para o combate à pandemia de Covid-19. No entanto, é necessário que eles sejam interpretados e divulgados de forma responsável, sem a intenção de manipular ou distorcer a realidade. Juntos, podemos lutar contra a desinformação e trabalhar em prol de um futuro melhor para todos.